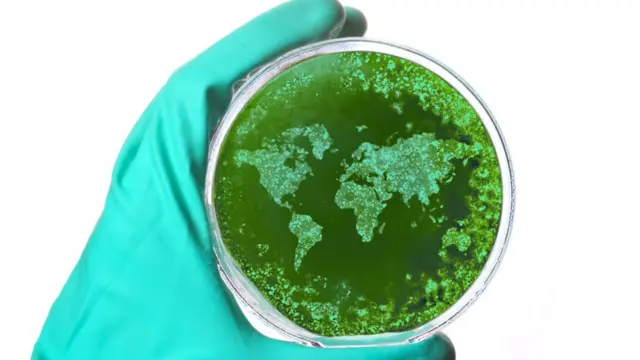
virus

Los "peligrosos experimentos" financiados por EE.UU. que según algunos científicos podrían desatar una pandemia

Fuente de la imagen, Getty
- Autor, Carlos Serrano (@carliserrano)
- Título del autor, BBC Mundo
- Tiempo de lectura: 5 min
Si algo falla, el desenlace podría ser catastrófico.
Esa es la alerta que lanza un grupo de científicos estadounidenses, quienes advierten que el gobierno de ese país está financiando con dineros públicos unos "peligrosos experimentos" que podrían desatar una pandemia.
De hecho, el riesgo que implican estas investigaciones había llevado a que se suspendieran hace cuatro años, pero ahora las autoridades han vuelto a dar vía libre para que se desarrollen.
Se trata de unos controvertidos estudios de laboratorio en los que se manipulan cepas del virus mortal de la gripe aviar.
El peligro, según los críticos, es que estos experimentos podrían abrir la puerta para que estos virus altamente contagiosos -algunos de los cuáles no se han transmitido en humanos-, puedan contagiar a miles de personas.
"De hecho, la razón de ser de estos experimentos es hacer el virus contagioso para los humanos", le dice a BBC Mundo Marc Lipsitch, profesor de epidemiología en la Escuela de Salud pública de la Universidad de Harvard y uno de los críticos de estos estudios.

Fuente de la imagen, Getty
"Tienen poco valor científico, pero un riesgo inusualmente alto", dice Lipsitch. "Realmente no se por qué los están haciendo".
¿En qué consisten estas investigaciones, cuál es su objetivo y por qué son tan polémicas?
Aprender sobre el virus
Uno de los proyectos en la mira se desarrolla en la Universidad de Wisconsin, con fondos de los Institutos Nacionales de Salud (NIH, por sus siglas en inglés), la agencia pública de investigaciones médicas de EE.UU.
Los experimentos incluyen, por ejemplo, infectar hurones con el virus de la gripe aviar H5N1 y ver si el virus se transmite de un animal a otro.
Este virus resulta altamente mortal para los humanos, pero hasta ahora no se ha reportado que se transmita de persona a persona.
El objetivo, según los investigadores, es aprender más sobre cómo se propaga el virus y así prever formas de detener su propagación en los mamíferos.
La idea es preparar a los humanos para este tipo de virus.

Fuente de la imagen, Getty
"La única manera de detener una pandemia es tener un mayor conocimiento científico de cómo se transmiten estos virus", le dice a BBC Mundo Rebecca Moritz, microbióloga experta en bioseguridad, quien supervisa este tipo de experimentos en la Universidad de Wisconsin.
"El objetivo no es crear intencionalmente un virus que se pueda transmitir".
Pero ese no es el mayor temor de Lipsitch.
Según él, es poco probable que alguien quiera usar el virus como un arma, o que ocurra una explosión en el laboratorio o una falla en el sistema de ventilación que haga que el virus se libere.
"Lo que sí es más probable", dice, "es que alguien cometa un error y quede expuesto a estos virus, lo transmita a otra persona y así comience un brote".
"En la mayoría de los casos en los que alguien quedó expuesto a patógenos peligrosos fue porque pensaba que estaba trabajando con material seguro".
Lipsitch reconoce que el riesgo de que este experimento desate por accidente una pandemia es bajo, "pero eso no equivale a que sea seguro hacerlo".
Moritz, por su parte, sostiene que el proyecto es seguro y que representa un riesgo "increíblemente bajo" y gracias a ello recibió la financiación del NIH.
Fuente de la imagen, Getty
¿Por qué hacerlo de esa manera?
Hay muchas formas de hacer experimentos con virus, pero según Lipsitch, en este caso se escogió la menos conveniente.
"Si te quieres preparar para una pandemia, hay muchas cosas que puedes hacer, todas ellas seguras, excepto este tipo de trabajo", dice.
Para él, aunque los experimentos con virus siempre tienen un riesgo, hay otros métodos que tienen más sentido.
Una opción, por ejemplo, sería tomar una cepa de gripe humana e introducirle cambios para hacerla más parecida a la gripe aviar y luego tratar de reparar esos cambios.
Este método es costoso y complicado, así que según Lipsitch, mejor sería comparar cepas de gripe aviar y gripe humana, analizar sus propiedades y estudias sus diferencias.
"Eso daría pistas sobre qué causa que los humanos se adapten".
Moritz, una vez más, no está de acuerdo.

Fuente de la imagen, Getty
"Esas metodologías no pueden llevarte muy lejos", dice. "Los virus de la influenza son increíblemente diversos, así que no es que necesariamente puedas sustituir un virus de la influenza con otro virus de la influenza".
Transparencia
Quienes se oponen a estas investigaciones también reclaman que no fue claro el proceso mediante el cual el gobierno las autorizó.
En BBC Mundo enviamos preguntas al NIH sobre los experimentos y su proceso de aprobación, pero no obtuvimos respuesta inmediata.
El Departamento de Salud y Servicios Humanos de EE.UU. (HHS, por sus siglas en inglés), del cual depende el NIH, llevó a cabo una revisión a cargo de un grupo de expertos, quienes concluyeron que era seguro darle luz verde a las investigaciones.
Sin embargo, un portavoz del HHS citado por la revista Science advierte que no se pueden publicar las conclusiones del panel, porque contienen información confidencial del laboratorio que va a desarrollar los experimentos, la cual podría beneficiar a sus competidores.
Para Lipsitch, esa decisión privilegia los secretos comerciales de unos pocos científicos, por encima del derecho de los ciudadanos a conocer iniciativas que los podrían afectar.

Fuente de la imagen, Getty
Richard Ebrigh, microbiólogo de la Universidad de Rutgers citado por Science, dice que esta falta de apertura es "perturbadora e indefendible".
Moritz defiende el proyecto y afirma que el proceso de revisión fue transparente e incluyó el concepto de expertos internacionales y audiencias públicas.
¿Vale la pena el riesgo?
Según reporta Science, quienes trabajan en esta investigación deben cumplir con unas normas que incluyen: avisar de inmediato a las autoridades si identifican una cepa de H5N1 altamente peligrosa y que se pueda transmitir entre los hurones a través del aire; o si desarrollan un agente contaminante que sea resistente a las drogas antivirales.
"Creo que alguien está exagerando el valor de este experimento o simplemente decidieron hacerlo sin importar los riesgos", dice Lipsitch.
Por su parte, el proyecto sigue avanzando, aunque según Moritz aún no hay una fecha específica en la que tengan que mostrar los primeros resultados.
Mientras tanto Lipsitch insiste en que es un riesgo que no vale la pena tomar.
"Cualquier experimento que ponga en riesgo la vida de un humano, debe ser uno de los experimentos más importantes del siglo, debe ser algo muy especial", dice, "y nadie ha explicado qué tiene de especial este experimento".

Contenido no disponible
Ver más en FacebookLa BBC no se hace responsable del contenido de sitios externos.Fin del contenido de Facebook

Ahora puedes recibir notificaciones de BBC Mundo. Descarga la nueva versión de nuestra app y actívalas para no perderte nuestro mejor contenido.
Este artículo contiene contenido proporcionado por Google YouTube. Solicitamos tu permiso antes de que algo se cargue, ya que ese sitio puede estar usando cookies y otras tecnologías. Es posible que quieras leer política de cookies y política de privacidad de Google YouTube antes de aceptar. Para ver este contenido, selecciona 'aceptar y continuar'.
Fin del contenido de YouTube, 1
Este artículo contiene contenido proporcionado por Google YouTube. Solicitamos tu permiso antes de que algo se cargue, ya que ese sitio puede estar usando cookies y otras tecnologías. Es posible que quieras leer política de cookies y política de privacidad de Google YouTube antes de aceptar. Para ver este contenido, selecciona 'aceptar y continuar'.
Fin del contenido de YouTube, 2
Este artículo contiene contenido proporcionado por Google YouTube. Solicitamos tu permiso antes de que algo se cargue, ya que ese sitio puede estar usando cookies y otras tecnologías. Es posible que quieras leer política de cookies y política de privacidad de Google YouTube antes de aceptar. Para ver este contenido, selecciona 'aceptar y continuar'.
Fin del contenido de YouTube, 3









